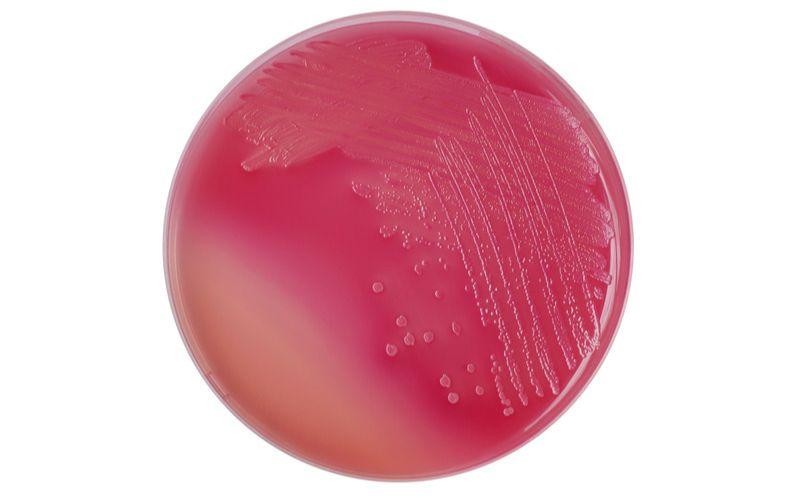

son los agentes selectivos que inhiben el desarrollo de gran parte de la flora Gram positiva. El agar es el agente solidificante. Por fermentación de la lactosa, disminuye el pH alrededor de la colonia. Esto produce un viraje del color del indicador de pH (rojo neutro), la absorción en las colonias, y la precipitación de las sales biliares.. El agar MacConkey se utiliza para el aislamiento de bacterias entéricas gramnegativas. Se utiliza en la diferenciación de la lactosa fermentada de bacterias gramnegativas no fermentadoras de lactosa. Se utiliza en el examen microbiológico de alimentos y para la siembra / inoculación directa de muestras de agua para el recuento de coliformes.

Lista 95+ Foto Bacterias Que Crecen En Agar Macconkey Lleno

MacConkey Agar Composition, Uses, Colony Characteristics • Microbe Online

Agar MacconKey Medio de cultivo sólido Selectivo y

Tipos de cultivo garcia vargas marcela Agar MacConkey con Cristal violeta El cristal violeta

Lista 91+ Foto Bacterias Que Crecen En Agar Macconkey El último

Lista 91+ Foto Bacterias Que Crecen En Agar Macconkey El último

Lista 91+ Foto Bacterias Que Crecen En Agar Macconkey El último

AGAR MACCONKEY Medio de cultivo sólido ppt video online descargar

Colonias bacterianas en placas de agar MacConkey Fotografía de stock Alamy
Agar MacConkey Ciencias de la tierra y de la vida

Lista 95+ Foto Bacterias Que Crecen En Agar Macconkey Lleno
MacConkey Agar for your Lab Needs! Biological Stains, Biological Products, Laboratory

MacConkey Agar MAC

Lista 91+ Foto bacterias que crecen en agar macconkey El último Dino English

Bacterias De Klebsiella Pneumoniae Que Crecen En Sangre Y Agar Maccono Imagen de archivo

MacConkey agar Alchetron, The Free Social Encyclopedia

Lista 91+ Foto Bacterias Que Crecen En Agar Macconkey El último

El agar MacConkey es un medio de cultivo selectivo y diferencial para bacterias. Está diseñado

Lista 91+ Foto Bacterias Que Crecen En Agar Macconkey El último
Agar MacConkey qué es, fundamento, usos y preparación
Mac Conkey Agar. B0411484. Este medio se utiliza para el aislamiento de bacilos Gram negati-vos de fácil desarrollo, aerobios y anaerobios facultativos a partir de muestras clínicas, aguas y alimentos. Todas las especies de Enterobacterales desarrollan en el mismo.. MacConkey II Agar. El crecimiento en el medio MacConkey II Agar indica la presencia de bacilos gram negativos, por ejemplo, Enterobacteriaceae (como E. coli y muchos otros de estos bacilos). CLED Agar y MacConkey II Agar sólo permiten una presunta diferenciación de las colonias conforme a la prueba de fermentación de la lactosa.